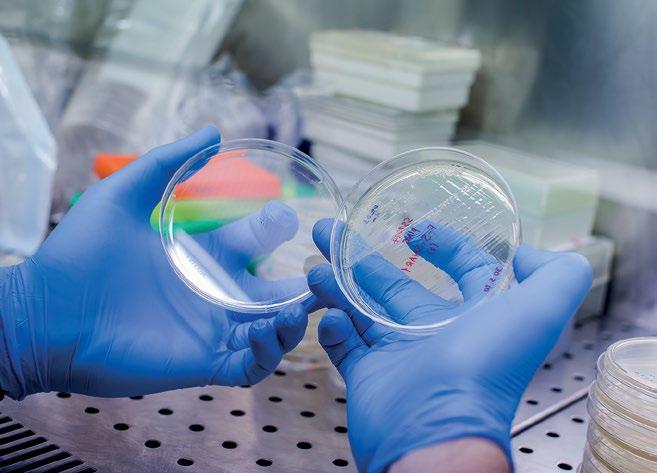

Think




● Πυρετός;
● Πονόδοντος;
● Συμπτώματα
● Πονόλαιμος;
● Ημικρανία;
● Πονοκέφαλος;
● Πόνοι περιόδου;
● Οσφυαλγία;
●
2107488821, Fax: 2107488827 info@winmedica.gr, www.winmedica.gr



6
16
20
22
32





36
56
62
38
boura.l@ethosmedia.eu
andrioti.m@ethosmedia.eu
42
Hodgkin
46
Waldenström
50
Λυσικράτους 64, 176 74
T: +30 210 998 4950
E: phb-press@ethosmedia.eu
www.virus.com.gr • www.phb.com.gr
ΓΕΜΗ: 00044774007000
• www.ethosmedia.eu
• www.ethosevents.eu
• www.banks.com.gr
• www.insuranceworld.gr
ISSN: 2241-0961


Eisai
Eisai και
που πλήττει τα νεαρά
Sarepta
Duchenne, DMD

Sarepta
Evaluate
Biogen με το lecanem-
για τη νόσο Αλτσχάιμερ, που εγκρί -
θηκε τον Ιανουάριο ως Leqembi, με ε-
κτιμώμενες πωλήσεις 3 δισ. δολ. έως
το 2028. Ωστόσο, θα πρέπει να κρατούν
«μικρό καλάθι», όπως έδειξε η πορεία
Aduhelm, το οποίο είχε προδιαγρα-

Η Apellis




Το Zuranolone της
Sage Therapeutics


Mirikizumab

Etrasimod

Acceleron το 2021,
οποία μπορεί να διασφαλίσει έως το 2028 πωλήσεις 1 δισ. δολαρίων.






Μέχρι




Jonsson Comprehensive Cancer Center.
οι θεραπείες μπορούν να συνεργαστούν για


(34%), lisocabtagene maraleucel (16%), axicabtagene
και τα συμπτώματα της διαταραχής μετατραυματικού στρες μετρήθηκαν χρησιμοποιώντας τη λίστα ελέγχου μετατραυματικού στρες. Οι ερευνητές κατέγραψαν επίσης σωματικά συμπτώματα χρησιμοποιώντας το Edmonton Symptom Assessment System, το οποίο αξιολόγησε τον πόνο, την κόπωση, την υπνηλία, τη
ναυτία, την όρεξη, τη δύσπνοια, την αϋ-
πνία, τη δυσκολία στην κατάποση και την
ευεξία σε διάστημα 24 ωρών.
Συνολικά, το 76% των ασθενών πέτυχε ύ-
φεση και το 33% εμφάνισε σύνδρομο νευ-
ροτοξικότητας, μια κοινή παρενέργεια της
θεραπείας

Η ομάδα έρευνας για τον καρκίνο ECOG-ACRIN ηγήθηκε της
δοκιμής με χρηματοδότηση από το Εθνικό Ινστιτούτο Καρκίνου (NCI), μέρος των Εθνικών Ινστιτούτων Υγείας των ΗΠΑ. Στη
δοκιμή συμμετείχαν και άλλες ομάδες δι-
κτύου
NCI.
Selina M. Luger,
σε 77 ιατρικά κέντρα σε ΗΠΑ,
μεταξύ του Δεκεμβρίου 2013 και του Ο-
κτωβρίου 2019. Οι ασθενείς με ανωμαλία του γονιδίου BCR::ABL1 δεν ήταν επιλέξιμοι. Η διάμεση ηλικία ήταν 51 έτη (εύρος 30-70).
Η καθιερωμένη θεραπεία της ΟΛΛ είναι περίπλοκη, με πολλαπλούς κύκλους συνδυασμών χημειοθεραπείας. Η επισκόπη-
E1910
2,5
Ενθαρρυντικά είναι τα ποσοστά ανταπόκρισης σε ηλικιωμένους ή
ασθενείς υψηλού
κινδύνου, καθώς η
νεοδιαγνωσθείσα
κοόρτη είχε 80%
συνολικό ποσοστό ανταπόκρισης.
το magrolimab.
Συνδυασμός ponatinibblinatumomab
Οι ασθενείς με οξεία λεμφοβλαστική



ανοσολογική απόκριση ανταγωνιζόμενα τα υγιή Β-κύτταρα κατά τη

Coraline Mlynarczyk,


κρίθηκε χειρουργήσιμο. Οι συμμετέ-
χοντες ηλικίας 18-90 ετών τυχαιοποιήθηκαν για να λάβουν είτε εκ των προτέρων
χειρουργική επέμβαση, ακολουθούμενη
από 200 mg pembrolizumab κάθε
Η CSL Behring
CSL Behring
CSL Behring:
We are unlocking
OJulia Ransohoff,




μετά τη διάγνωση του καρκίνου. Το 99% αυτών
των συνταγών ήταν για αντιβιοτικά. Ο δι-
άμεσος χρόνος παρακολούθησης για τη μελέτη ήταν 104 μήνες. Οι ερευνητές διαπίστωσαν ότι,
Ransohoff.





(hazard ratio, 0.59; 95% confidence interval [CI], 0.40 to 0.88; P=0.009).
93,9% (95% CI, 91.6 to 95.5) στην
A+AVD και 89,4% (95% CI, 86.6 to 91.7) στην ομάδα ABVD. Η
ABVD (hazard ratio για πρόοδο νόσου ή θάνατο, 0.68; 95% CI, 0.53 to 0.86). Λιγότεροι ασθενείς στην ομάδα A+AVD σε σχέση με την ομάδα ABVD έλαβαν
4 χ ABVD (δοξορουβικίνης, μπλεομυκίνης, βινμπλαστίνης και δα-
καρβαζίνης) σε PET2– και 4 χ BEACOPP
σε PET2+ ασθενείς.
Το PET μετά τους 4 κύκλους χημειοθερα-
πείας έπρεπε να είναι αρνητικό για να ολοκληρωθεί η προγραμματισμένη θεραπεία. Συνολικά, 823 ασθενείς συμμετείχαν
στη μελέτη, 413 στο τυπικό σκέλος και 410
στο σκέλος με το ενδιάμεσο PET. Με 67,2 μήνες διάμεσο χρόνο παρακολούθησης, η πενταετής επιβίωση χωρίς πρόοδο νό-
σου (87.5% v 86.7%; hazard ratio [HR] = 1.07; 95% CI, 0.74 με 1.57; P = .67) και
ολικής επιβίωσης (97.7% και στα δύο σκέλη; HR = 1.012; 95% CI, 0.50 με 2.10; P = .53) ήταν παρόμοια και στα δύο σκέλη τυχαιοποίησης.
Για το σύνολο των ασθενών, το ενδιάμεσο PET προέβλεπε την πενταετή PFS (92,3% σε PET2–/PET4–, 75,4% [HR = 3.26; 95% CI, 18.3 to 5.77] σε PET2+/PET4–και 46,5% [HR = 12.4; 95% CI, 7.31 to 19.51] σε PET4+ ασθενείς, αντίστοιχα; P < .0001) ανεξαρτήτως του διεθνούς προγνωστικού σκορ.
Η πενταετής ολική επιβίωση επηρεάστηκε επίσης από τα αποτελέσματα του ενδιάμεσου PET, και PET2+/PET4– ασθενείς (93.5%; HR = 3.3; 95% CI, 1.07 με 10.1; P = .036) και PET4+ ασθενείς (91.9%; HR = 3.756; 95% CI, 1.07 με 13.18; P = .038) είχαν σημαντικά μικρότερη ολική ε-
πιβίωση από τους PET2–/PET4– ασθενείς (98,2%). Εικοσιδύο ασθενείς (2,7%) εμφά-
νισαν δεύτερη πρωτοπαθή κακοήθεια, 13 (3,2%) και 9 (2,2%) στο τυπικό και στο πειραματικό σκέλος, αντίστοιχα. Η παρατεταμένη παρακολούθηση
θώρακος) οι
κλους δοξορουβικίνης, μπλεομυκίνης, βινμπλαστίνης και δακαρβαζίνης (ABVD) ακολουθούμενο από ενδιάμεσο PET (PET2). Οι ασθενείς με PET2–, που ορίζεται ως 1-
3 σε κλίμακα 5-βαθμών, έλαβαν ακόμα 4 κύκλους δοξορουβικίνης, μπλεομυκίνης, βινμπλαστίνης και δακαρβαζίνης. Ασθενείς
53% ήταν
30 έτη (εύρος 18-58 έτη). Ογδόντα-πέντε (90%) είχαν
II,
βανομένων 48 (51%) με στάδιο IIB/IIBE. Εβδομήντα-οκτώ (78%) ήταν PET2– και 21 (22%) και PET2+.
Βιβλιογραφία
1. Ansell, S.M., et al., Overall Survival with Brentuximab Vedotin in Stage III or IV Hodgkin’s Lymphoma. New England Journal of Medicine, 2022. 387(4): p. 310-320.
2. Bröckelmann, P.J., et al., Nivolumab and Doxorubicin, Vinblastine, and Dacarbazine in Early-Stage Unfavorable Hodgkin Lymphoma: Final Analysis of the Randomized German Hodgkin Study Group Phase II NIVAHL Trial. Journal of Clinical Oncology. 0(0): p. JCO.22.02355.
3. Casasnovas, R.-O., et al., Positron Emission Tomography–Driven Strategy in Advanced Hodgkin Lymphoma: Prolonged Follow-Up of the AHL2011 Phase III Lymphoma Study Association Study. Journal of Clinical Oncology, 2022. 40(10): p. 1091-1101.
4. LaCasce, A.S., et al., Positron Emission Tomography–Adapted Therapy in Bulky Stage I/II Classic Hodgkin Lymphoma: CALGB 50801 (Alliance). Journal of Clinical Oncology. 0(0): p. JCO.22.00947.
H(Dogliotti et al 2022).
(cfDNA)
(Castillo et al 2022).
(Khwala et al 2022).
Το 2022, δημοσιεύτηκαν τα αποτελέσματα μελετών που αξιολόγησαν την αποτελεσματικότητα νεότερων φαρμάκων σε ασθενείς με υποτροπιάζουσα/ανθεκτική
WM. Η ζανουμπρουτινίμπη είναι ένας νε -
ότερος αναστολέας της τυροσινικής κινά -
σης του Bruton και έδειξε ιδιαίτερα εν-
θαρρυντικά αποτελέσματα όσον αφορά στην αποτελεσματικότητα, την ασφάλεια και την ανοχή
στην ακαλαμπρουτινίμπη (Shadman et al 2022).
Η ορελαμπρουτινίμπη είναι

Βιβλιογραφία
Abushukair H, Syaj S, Ababneh O, et al. First- versus second-generation Bruton tyrosine kinase inhibitors in Waldenström’s Macroglobulinemia: A systematic review and meta-analysis. Am J Hematol. 2022;97(7):942-950.
Bagratuni T, Markou A, Patseas D, et al. Determination of MYD88L265P mutation fraction in IgM monoclonal gammopathies. Blood Adv. 2022;6(1):189-199.
Beaton B, Sasson SC, Rankin K, et al. Patients with treated indolent lymphomas immunized with BNT162b2 have reduced anti-spike neutralizing IgG to SARSCoV-2 variants, but preserved antigenspecific T cell responses. Am J Hematol. 2023;98(1):131-139.
Cao XX, Jin J, Fu CC, et al. Evaluation of orelabrutinib monotherapy in patients with relapsed or refractory Waldenström’s macroglobulinemia in a single-arm, multicenter, open-label, phase 2 study. EClinicalMedicine. 2022;52:101682.
Castillo JJ, Sarosiek SR, Gustine JN, et al. Response and survival predictors in a cohort of 319 patients with Waldenström macroglobulinemia treated with ibrutinib monotherapy. Blood Adv. 2022;6(3):10151024.
(Sekigushi et al 2022).
(Konishi et al 2022).
et al 2022).
(singlecell profiles) (Sun et al 2022).
Dogliotti I, Jiménez C, Varettoni M, et al. Diagnostics in Waldenström’s macroglobulinemia: a consensus statement of the European Consortium for Waldenström’s Macroglobulinemia Leukemia. 2022;10.1038/s41375-02201762-3.
Khwaja J, Uppal E, Baker R, et al. Bortezomib-based therapy is effective and well tolerated in frontline and multiply pre-treated Waldenström macroglobulinaemia including BTKi failures: A real-world analysis. EJHaem. 2022;3(4):1330-1334.
Konishi Y, Sklavenitis-Pistofidis R, Yue H, et al. Attenuated response to SARS-CoV-2 vaccine in patients with asymptomatic precursor stages of multiple myeloma and Waldenström macroglobulinemia. Cancer Cell. 2022;40(1):6-8.
Riva E, Duarte PJ, Valca‘rcel B, et al. Treatment and Survival Outcomes of Waldenström Macroglobulinemia in Latin American Patients: A Multinational Retrospective Cohort Study. JCO Glob Oncol. 2022;8:e2100380.
Rosati M, Terpos E, Bear J, et al. Low Spike Antibody Levels and Impaired BA.4/5 Neutralization in Patients with Multiple Myeloma or Waldenström’s Macroglobulinemia after BNT162b2
Booster Vaccination. Cancers (Basel). 2022;14(23):5816.
Sekiguchi N, Rai S, Munakata W, et al. Twoyear outcomes of tirabrutinib monotherapy in Waldenström’s macroglobulinemia. Cancer Sci. 2022;113(6):2085-2096.
Shadman M, Flinn IW, Levy MY, et al. Zanubrutinib in patients with previously treated B-cell malignancies intolerant of previous Bruton tyrosine kinase inhibitors in the USA: a phase 2, open-label, singlearm study. Lancet Haematol. 2022;S23523026(22)00320-9.
Sun H, Fang T, Wang T, et al. Single-cell profiles reveal tumor cell heterogeneity and immunosuppressive microenvironment in Waldenström macroglobulinemia. J Transl Med. 2022;20(1):576.
Terpos E, Fotiou D, Karalis V, et al. SARSCoV-2 humoral responses following booster BNT162b2 vaccination in patients with B-cell malignancies. Am J Hematol. 2022;97(10):1300-1308.
Tomowiak C, Leblond V, Laribi K, et al. Response to vaccination against SARSCoV-2 in 168 patients with Waldenström macroglobulinaemia: A French Innovative Leukaemia Organization study. Br J Haematol. 2022;197(4):424-427.

αυτόλογη μεταμόσχευση, έναντι
46,2 για αυτούς που δεν υποβλήθηκαν σε
μεταμόσχευση. Ο κίνδυνος προόδου νόσου
ή θανάτου ήταν μεγαλύτερος στους ασθε-
νείς που δεν υποβλήθηκαν σε αυτόλογη
μεταμόσχευση κατά 53% (HR, 1.53; 95% CI, 1.23 - 1.91, P<0.001). Το συνολικό πο-
σοστό ανταπόκρισης ήταν 97,5% και 95%,
αντίστοιχα (p=0.55), με 46,8% και 42%
να πετυχαίνουν πλήρη ύφεση (p=0.99).
Όμως, δεν υπήρχε διαφορά στην επιβίω-
στα 5 έτη, που ήταν 80,7% και 79,2%,
(HR:1.10; 95% CI, 0.73 - 1.65)2
ήταν
και το ποσοστό πλήρους
ήταν 39,4%, ενώ 26,7% πέτυ-
ήταν 11,3 μήνες (95% CI, 8,8-17.1).
Οι συχνότερες ανεπιθύμητες ενέργειες ή-
(στο 72,1% των ασθενών και μόνο
στο 0,6% ήταν βαθμού 3), η αιματολογική τοξικότητα


1. D'AGOSTINO, CAIRNS, LAHUERTA, et al. Second Revision of the International Staging System (R2-ISS) for Overall Survival in Multiple Myeloma: A European Myeloma Network (EMN) Report Within the HARMONY Project. J Clin Oncol. Oct 10; 40(29): 34063418.
2. RICHARDSON, JACOBUS, WELLER, et al. Triplet Therapy, Transplantation, and Maintenance until Progression in Myeloma. N Engl J Med. Jul 14; 387(2): 132-147.
3. GOLDSCHMIDT, MAI, BERTSCH, et al. Addition of isatuximab to lenalidomide, bortezomib, and dexamethasone as induction therapy for newly diagnosed, transplantation-eligible patients with multiple myeloma (GMMG-HD7): part 1 of an open-label, multicentre, randomised, active-controlled, phase 3 trial. Lancet Haematol. Nov; 9(11): e810-e821.
4. COSTA, CHHABRA, MEDVEDOVA, et al. Daratumumab, Carfilzomib, Lenalidomide, and Dexamethasone With Minimal Residual Disease Response-Adapted Therapy in Newly Diagnosed Multiple Myeloma. J Clin Oncol. Sep 1; 40(25): 2901-2912.
5. MINA, MUSTO, ROTA-SCALABRINI, et al. Carfilzomib induction, consolidation, and
maintenance with or without autologous stem-cell transplantation in patients with newly diagnosed multiple myeloma: preplanned cytogenetic subgroup analysis of the randomised, phase 2 FORTE trial. Lancet Oncol. Jan; 24(1): 64-76.
6. SAN-MIGUEL, AVET-LOISEAU, PAIVA, et al. Sustained minimal residual disease negativity in newly diagnosed multiple myeloma and the impact of daratumumab in MAIA and ALCYONE. Blood. Jan 27; 139(4): 492-501.
7. DIMOPOULOS, DYTFELD, GROSICKI, et al. Elotuzumab Plus Pomalidomide and Dexamethasone for Relapsed/Refractory Multiple Myeloma: Final Overall Survival Analysis From the Randomized Phase II ELOQUENT-3 Trial. J Clin Oncol. Jan 20; 41(3): 568-578.
8. USMANI, QUACH, MATEOS, et al. Carfilzomib, dexamethasone, and daratumumab versus carfilzomib and dexamethasone for patients with relapsed or refractory multiple myeloma (CANDOR): updated outcomes from a randomised, multicentre, open-label, phase 3 study. Lancet Oncol. Jan; 23(1): 65-76.
9. LONIAL, POPAT, HULIN, et al. Iberdomide plus dexamethasone in heavily pretreated late-line relapsed or refractory
multiple myeloma (CC-220-MM-001): a multicentre, multicohort, open-label, phase 1/2 trial. Lancet Haematol. Nov; 9(11): e822-e832.
10. MOREAU, GARFALL, VAN DE DONK, et al. Teclistamab in Relapsed or Refractory Multiple Myeloma. N Engl J Med. Aug 11; 387(6): 495-505.
11. BAHLIS, TOMASSON, MOHTY, et al. Efficacy and Safety of Elranatamab in Patients with Relapsed/Refractory Multiple Myeloma Naïve to B-Cell Maturation Antigen (BCMA)-Directed Therapies: Results from Cohort a of the Magnetismm-3 Study. Blood. 140(Supplement 1): 391-393.
12. CHARI, MINNEMA, BERDEJA, et al. Talquetamab, a T-Cell-Redirecting GPRC5D Bispecific Antibody for Multiple Myeloma. N Engl J Med. Dec 15; 387(24): 2232-2244.
13. MAILANKODY, DEVLIN, LANDA, et al. GPRC5D-Targeted CAR T Cells for Myeloma. N Engl J Med. Sep 29; 387(13): 1196-1206.
14. KFIR-ERENFELD, ASHERIE, GRISARIU, et al. Feasibility of a Novel Academic BCMA-CART (HBI0101) for the Treatment of Relapsed and Refractory AL Amyloidosis. Clin Cancer Res. Dec 1; 28(23): 5156-5166.


και καρδιολογικών επιπλοκών.
To 2022, παρουσιάστηκαν τα δεδομένα από τη διπλή τυφλή τυχαιοποιημένη πολυ-
κεντρική μελέτη Φάσης ΙΙΙ MOMENTUM5, η οποία αξιολόγησε την ασφάλεια και την
αποτελεσματικότητα του momelotinib, ενός αναστολέα του JAK1, JAK2 και του ACVR1 (activin A υποδοχέας τύπου Ι). Η χορήγη-
ση του momelotinib αξιολογήθηκε έναντι
To avapritinib
Εγκρίθηκε
EXPLORER και PATHFINDER.

Πλέον, ορίζονται και χρησιμοποιούνται ως όροι το ΜΔΣ με χαμηλό ποσοστό βλαστών (MDS-LB) και το ΜΔΣ με αυξημένο ποσοστό βλαστών (MDS-IB).
Προτείνεται επίσης και νέο προγνωστικό σκορ για τους ασθενείς με Μυελοδυσπλα-
στικά Σύνδρομα (ΜΔΣ), το IPSS-Mοlecular (M), το οποίο είναι ένα επικυρωμένο σκορ
που περιλαμβάνει κυτταρογενετικά και
μοριακά χαρακτηριστικά των προηγούμενων προγνωστικών σκορ και βασίζεται
παρουσία μεταλλάξεων. Σε μια ανά-
3.000 ασθενών με ΜΔΣ, το IPSS-M

πο-
λύ χαμηλό, χαμηλό και ενδιάμεσο κίνδυνο που έχουν δακτυλιοειδείς σιδηροβλάστες,
οποίοι
μη ικανοποιητική ανταπόκριση σε ή είναι ακατάλληλοι για θερα-
πεία που βασίζεται στην ερυθροποιητίνη.
Συνολικά, 229 ασθενείς τυχαιοποιήθηκαν για να λαμβάνουν υποδορίως luspatercept 1,0 mg/kg (n=153) ή εικονικό φάρμακο (n=76) κάθε 3 εβδομάδες.

που έλαβε τον συνδυασμό ivosidenib-αζακιτιδίνη έναντι 7,9 μηνών για την ομάδα
που έλαβε εικονικό φάρμακο-αζακιτιδίνη (HR 0.44; 95% CI 0.27 to 0.73; p=0.001).
Οι συχνότερες ανεπιθύμητες ενέργειες (βαθμού 3+) ήταν το ουδετεροπενικό εμπύρετο, η ουτεροπενία και οι αιμορρα-
γικές επιπλοκές. Η επίπτωση λοιμώξεων οποιουδήποτε βαθμού ήταν 28% στην ομάδα του συνδυασμού έναντι 49% στην
που έλαβε εικονικό φάρμακο
εκλογής για
2022, έλαβε έγκριση από τον FDA το olutasidenib, ένας ακόμα αναστολέας του μεταλλαγμένου ισοενζύμου του IDH1 για
1. KHOYRY JD, SOLARY E, ABLA O, et al. The 5th edition of the World Health Organization Classification of Haematolymphoid Tumours: Myeloid and Histiocytic/Dendritic Neoplasms. Leukemia. 2022;36(7):1703.
2. MESA RA, VANNUCCHI AM, MEAD A, et al. Pacritinib versus best available therapy for the treatment of myelofibrosis irrespective of baseline cytopenias (PERSIST-1): an international, randomised, phase 3 trial. Lancet Haematol. 2017;4(5):e225-e236.
3. MASCARENHAS J, HOFFMAN R, TALPAZ M, et al. Pacritinib vs best available therapy, including ruxolitinib, in patients with myelofibrosis: a randomized clinical trial. JAMA Oncol. 2018;4(5):652-659.
4. GERDS AT, SAVONA MR, SCOTT BL, et al. Determining the recommended dose of pacritinib: results from the PAC203 dosefinding trial in advanced myelofibrosis. Blood Adv. 2020 Nov 24;4(22):5825-5835.
5. MESA RA, GERDS AT, VANNUCCHI A, et al. MOMENTUM: phase 3 randomized study of momelotinib (MMB) versus danazol (DAN) in symptomatic and anemic myelofibrosis (MF) patients previously treated with a JAK inhibitor. J Clin Oncol. 2022;40(suppl 16):7002.
6. Blueprint Medicines’ AYVAKYT (avapritinib) receives European Commission approval for the treatment of adults with advanced systemic mastocytosis. News release. Blueprint Medicines Corporation; March 25, 2022. Accessed March 25, 2022. https://prn. to/3iybxp4
7. DEANGELO DJ, RADIA DH, GEORGE TI, et al. Safety and efficacy of avapritinib in advanced systemic mastocytosis: the phase 1 EXPLORER trial. Nature Medicine. 2021;27: 2183–2191
8. GOTLIB L, REITER A, RADIA H, et al. Efficacy and safety of avapritinib in advanced systemic mastocytosis: interim analysis of the phase 2 PATHFINDER trial. Nature Medicine. 2021;27:2192–2199.
9. GOTLIB L, KILADJIAN JJ, VANNUCCHI A, et al. A Phase 2 Study of Pemigatinib (FIGHT-203; INCB054828) in Patients with Myeloid/Lymphoid Neoplasms (MLNs) with Fibroblast Growth Factor Receptor 1 (FGFR1) Rearrangement (MLN FGFR1). Blood. 2021;138: 385.
10. SANTINI V, FENAUX P, ZEIDAN AM, et al. Overall survival and progression-free survival of patients following luspatercept treatment in the MEDALIST trial. Presented at ASH 2022; December 10-13, 2022. Abstract 1774.
11. CADENAS FL, LUMBRERAS E, GONZALEZ T, et al. Evaluation of lenalidomide (len) vs placebo in nontransfusion dependent low risk del(5q) MDS patients. Final results of Sintra-REV phase III international multicenter clinical trial. Presented at ASH 2022. December 10-13, 2022. Abstract 460
12. LEE S, MOHAN S, KNUPP J, et al. Oral eltanexor treatment of patients with higher-risk myelodysplastic syndrome refractory to hypomethylating agents. J Hematol Oncol. 2022 Aug 3;15(1):103.
13. MONTESINOS P, RECHER C, VIVES S, et al. Ivosidenib and Azacitidine in IDH1Mutated Acute Myeloid Leukemia. N Engl J Med 2022; 386:1519.
14. CORTES JE, FENAUX P, YEE K, et al. Olutasidenib (FT-2102) Induces Durable Complete Remissions in Patients with Relapsed/Refractory mIDH1 Acute Myeloid Leukemia. Results from a Planned Interim Analysis of a Phase 2 Pivotal Clinical Trial. Blood (2022) 140 (Supplement 1): 61936196.
TΗ μελέτη BEYOND

το πρωτεύον καταληκτικό σημείο της μελέτης, αύξηση της μέσης αιμοσφαιρίνης από
την τιμή αναφοράς ≥1,0 g/dL, έναντι 0
από τους 49 (0%) ασθενείς στο σκέλος θεραπείας με εικονικό φάρμακο (P<0,0001).
Σε ένα δευτερεύον καταληκτικό σημείο της
μελέτης, 47 από τους 96 ασθενείς (49,0%)
που έλαβαν θεραπεία με luspatercept πέτυχαν μέση αύξηση της αιμοσφαιρίνης ≥1,5 g/dL
ανεπιθύμητες ενέργειες εμφα-
νίστηκαν στο 11,5% των ασθενών (n=11)
που έλαβαν θεραπεία με luspatercept. Οι
πιο συχνές ανεπιθύμητες ενέργειες που α-
ναφέρθηκαν σε ≥10% των ασθενών ήταν
οστικός πόνος (36%), κεφαλαλγία (30%),
αρθραλγία (29%), οσφυαλγία (28%), προ-
ϋπέρταση (23%), υπέρταση (20%), βήχας (18%), διάρροια (17%), γριπώδης συνδρο-
(17%), εξασθένηση (13%), γρίπη (13%),
(11%) και ναυτία (10%).



analyses on the WHO Global Health Observatory,
της υγείας (ΠΟΥ). Έχει τεκμηριωθεί ότι οι κοινωνι-



ενδια-
φερόμενους φορείς.
Την ίδια ώρα, τεράστιες ποσότητες δεδομένων υγείας παράγονται και αποθηκεύονται σε διάφορες πηγές καθημερινά για
πιθανή χρήση. Έτσι, από την προοπτική
του EHDS και σε συνεργασία με τα κρά-
τη μέλη, φιλοδοξία είναι να δημιουργη-

για άλλους σκοπούς.
Θα μπορούσε να γίνει περισσότερο
άρθρου 5 παράγραφος 1 στοιχείο β)
σε μεγαλύτερο βαθμό και υπό


πληροφοριών–θα πρέπει να συμπεριληφθούν σε πρώιμο στάδιο.






ασφαλείας (57%), να κλειδώνει με κωδικό (48%), να έχει αναγνώ-
δακτυλικού αποτυπώματος
(17%)
(12%).



























